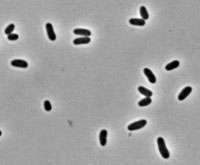

Corynebacterium glutamicum
| Corynebacterium glutamicum | |
|---|---|
![]() | |
| C. glutamicum under phase contrast | |
| Scientific classification | |
| Kingdom: | Bacteria |
| Phylum: | Actinobacteria |
| Order: | Actinomycetales |
| Suborder: | Corynebacterineae |
| Family: | Corynebacteriaceae |
| Genus: | Corynebacterium |
| Binomial name | |
| Corynebacterium glutamicum | |
Corynebacterium glutamicum is a Gram-positive, rod-shaped bacteria which is used industrially for large-scale production of amino acids.[1] While originally identified in a screen for organisms secreting L-glutamate, mutants of C. glutamicum have also been identified which produce various other amino acids.[2]
Due to its industrial importance, several clones of C. glutamicum have been sequenced by both industry and academic groups.[1]
See also
List of sequenced bacterial genomes
References
- 1 2 Kalinowski, J; Bathe, B; Bartels, D; Bischoff, N; Bott, M; et al. (4 September 2003). "The complete Corynebacterium glutamicum ATCC 13032 genome sequence and its impact on the production of l-aspartate-derived amino acids and vitamins". Journal of Biotechnology. 104 (1-3): 5–25. doi:10.1016/S0168-1656(03)00154-8. PMID 12948626.
- ↑ Zahoor A; Lindner SN; Wendisch VF (October 2012). "Metabolic Engineering of Corynebacterium glutamicum Aimed at Alternative Carbon Sources and New Products". Computational and Structural Biotechnology Journal. 3 (4): 1–11. doi:10.5936/csbj.201210004. PMID 24688664.
External links
- Genome sequence for C. glutamicum from NCBI.
- Type strain of Corynebacterium glutamicum at BacDive - the Bacterial Diversity Metadatabase
This article is issued from Wikipedia - version of the 11/8/2016. The text is available under the Creative Commons Attribution/Share Alike but additional terms may apply for the media files.